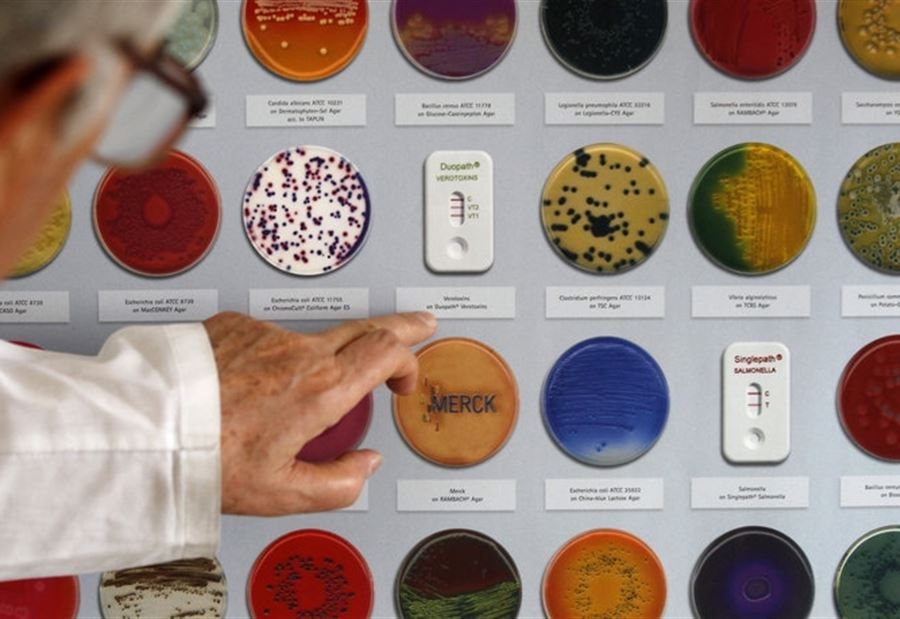
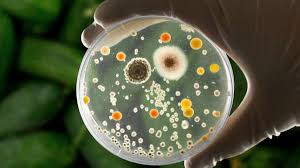

وكإجراء احترازي ، أكدت الشركة المالكة لسلسلة المطاعم أنه "تم استبدال الخس في السندويشات في بعض المناطق المتضررة".
❤️سرعة المبادرة تزيد من ثقة عملائك
@rattibha
❤️سرعة المبادرة تزيد من ثقة عملائك
@rattibha
جاري تحميل الاقتراحات...